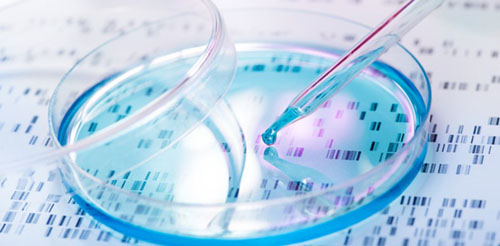

電力在生物過程中的作用與其在技術中的作用一樣重要,并且已通過許多微妙而有趣的方式被用于科學用途。電泳是生物化學中廣泛使用的一種技術,電泳是利用電流來操縱蛋白質分子,以用于一系列生物醫學研究,診斷和制造目的。
有機分子通常帶有正電荷或負電荷,這會使它們對電流作出響應。帶正電荷的分子向電場的負極遷移,帶負電荷的分子向正極遷移。電荷較大的分子在施加電荷時趨向于更快地移動并傳播更遠。但是,它們也會因摩擦而減慢,而摩擦又受分子的大小和形狀以及測試所用介質的影響。通過控制電流和測試介質提供的摩擦力,研究人員可以創建有效分離生物分子的條件,從而可以對它們進行分離和研究。通過觀察電流對分子的影響,研究人員還可以識別分子之間的差異。
電泳儀的一種主要用途是鑒定和研究DNA和DNA片段。DNA以其負電荷的一致性而著稱,這意味著電流向DNA的任何部分施加大致相等的力。在這種壓力下,DNA的較大和較小片段開始分離,因為它們受測試介質的摩擦力的影響會有所不同。當除去電流時,通常是瓊脂糖凝膠或丙烯酰胺凝膠的介質會將分離的片段“凍結”在適當的位置,從而可以高分辨率對其進行檢查。通常將染色劑(如溴化乙錠)添加到凝膠中,以使其更易于查看和解釋結果。
電泳的另一種常見形式是免疫電泳,它可以分析某些蛋白質的存在和行為。許多醫學狀況,包括多發性硬化癥,腎臟疾病和某些癌癥,都會導致蛋白質分子異常的產生。可以通過對尿液或血液樣本進行電泳并觀察與正常蛋白質數量和類型的差異來檢測這些蛋白質。免疫電泳還可用于檢測稱為抗體的特定蛋白質,稱為免疫球蛋白。這些是人體免疫系統的一部分,會攻擊外來蛋白質,例如病毒或過敏原。分析這些抗體可以幫助您找到治療這些入侵者的新療法,還可以洞悉過敏和自身免疫性疾病等疾病,
電泳在抗生素測試中起著許多作用。最常見的方法之一是測試抗生素的純度。通過對含有抗生素的溶液進行電泳,該溶液呈浸有抗生素的紙條或充滿溶液的毛細管(非常細的管)的形式,研究人員可以區分抗生素本身和任何雜質。他們還可以確定抗生素的濃度,這對于精確劑量至關重要。抗生素研究擴展到基因測試領域,確定可能表明對特定抗生素具有抗性的基因。
與抗生素一樣,電泳在疫苗的生產和生產中都是有用的。疫苗的目的是幫助人體產生針對潛在危險病原體的抗體,而電泳是檢測這些抗體的有用方法。研究人員可以使用該技術在大量測試對象或其他變量之間比較疫苗或疫苗多種版本的效果。疫苗生產后,電泳儀還提供了一種快速有效的方法來測試生產批次的一致性和純度。